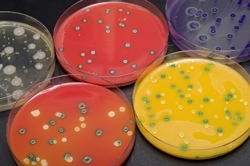

Visualizar la infección bacteriana
Listeria monocytogenes es una bacteria patógena que provoca la Listeriosis, una infección potencialmente mortal que afecta principalmente a personas inmunodepremidas, incluyendo a mujeres embarazadas y sus fetos. Esta bacteria vive en las células y se dispersa a las células vecinas por medio de la modificación del citoesqueleto de actina de las células hospedadoras.Los socios del proyecto financiado por la Unión Europea «Cytoskeleton architecture in host cells during Listeria infection using cryo-electron tomography» (3DCELLART) estudiaron en detalle los cambios que acontecen en el citoesqueleto de las células hospedadoras durante la infección por Listeria.La tomografía crioelectrónica (cryo-ET) permite la visualización de la estructura de células vivas a una resolución mejor de cinco nanómetros (nm). Los investigadores emplearon esta tecnología para visualizar la reorganización del citoesqueleto en las células infectadas por Listeria. Las medidas se realizaron a criotemperaturas en muestras celulares preservadas en un estado próximo a la vida.El análisis cuantitativo de la estructura supramolecular mostró la existencia de haces de filamentos empaquetados casi paralelamente, formando una red hexagonal con una separación de doce a trece nm. Los investigadores también confirmaron la existencia de configuraciones parecidas en la actina de las fibras de estrés y de los filopodios. Este resultado sugiere que los haces nanoscópicos son una característica común del ensamblaje de los filamentos de actina implicados en la motilidad, ya que estos filamentos proporcionan la rigidez necesaria. Esta característica común de la estructura de los filamentos de actina tiene importantes implicaciones para el mecanismo de generación de propulsión. Los resultados han sido publicados en una revista científica de gran impacto. Las investigaciones del proyecto 3DCELLART constituyen un gran avance en el campo de la investigación de las enfermedades infecciosas bacterianas, y proporcionan datos únicos de tomografía crioelectrónica en células eucariotas infectadas por una bacteria patógena. Los resultados del proyecto podrían proporcionar nuevas dianas moleculares para el desarrollo de antibióticos novedosos.